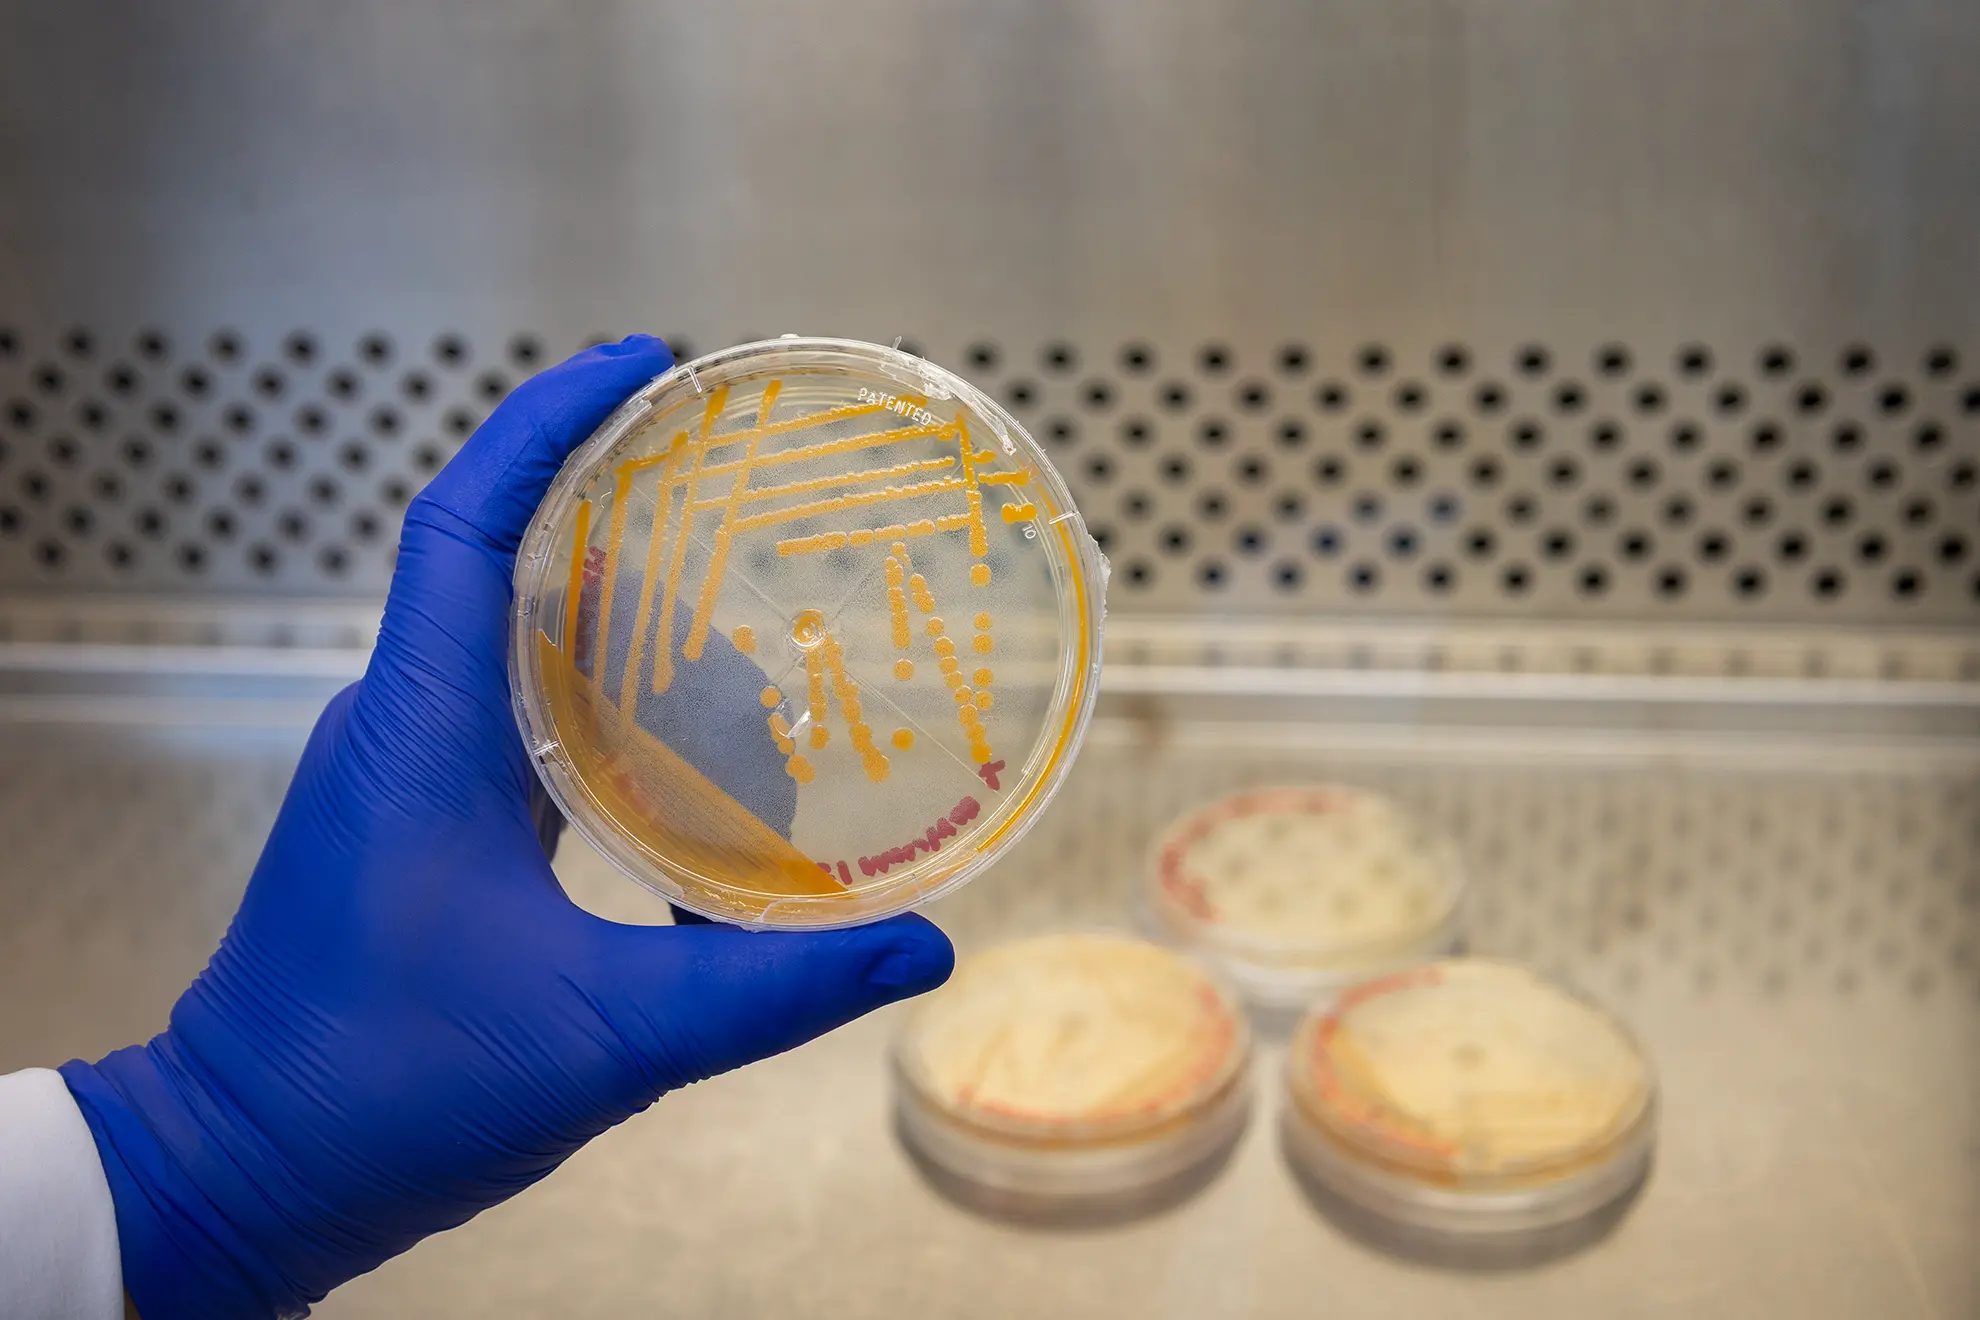
Bacteriología

UMG LABS un espacio donde la ciencia, la tecnología y la precisión se unen para brindar soluciones confiables al servicio de la salud. Nuestro Laboratorio Clínico cuenta con una amplia gama de áreas especializadas, como hematología, inmunología, pruebas bioquímicas, así como estudios de enfermedades autoinmunes a través de marcadores tumorales, y otros análisis como pruebas de heces y orina y pruebas rápidas, contando así con una amplia gama de pruebas relacionadas a la salud de nuestros pacientes. Cada examen es realizado con equipos modernos, protocolos rigurosos y personal altamente capacitado, comprometido con el bienestar de los pacientes y el respaldo confiable al diagnóstico médico.
Escribe el nombre del estudio para saber preparaciones y detalles.

Puedes contactárnos buscándonos por Waze, escribiendo a nuestro correo electrónico o completando este formulario de contacto.